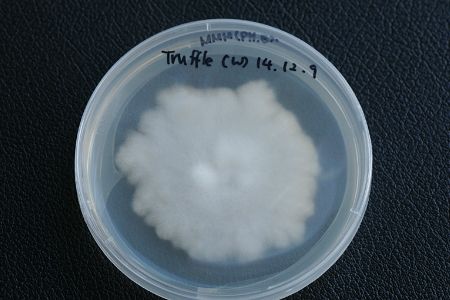

서양 송로버섯인 트뤄프 균사체(사진=전남 산림자원 연구소 제공)
서양 송로버섯인 트뤄프 균사체(사진=전남 산림자원 연구소 제공)
전라남도 산림자원연구소가 새 소득자원 발굴을 위해 서양 송로버섯인 트뤼프(Truffle)의 균사체 대량증식 기술 개발에 속도를 내고 있다.
트뤼프는 참나무류 뿌리와 공생하면서 땅 속에서 자생하는 귀한 버섯이다.
세계 3대 식재료 가운데 하나로 맛과 향이 뛰어나 가격이 100g당 수백만 원을 넘는 고가의 버섯이다.
하지만 국내에서는 아직 발견되지 않고 있다.
색깔에 따라 검정(Black Truffle)과 흰색(White Truffle) 두 종류로 나뉘며, 최근 맛과 향이 우수한 흰색 트뤼프 수요가 늘고 있다.
이에 전라남도 산림자원연구소는 트뤼프 대량 인공재배를 위해 2014년 유럽에서 트뤼프을 직접 채취해와 균 분리 및 배양에 성공했으며, 현재는 트뤼프를 묘목에 인공적으로 접종해 기르는 기술인 '인공접종묘' 연구를 진행하고 있다.
올해는 농림축산식품부 연구개발(R&D) 사업 공모과제에 선정돼 국비 5천만 원을 확보, 한국농수산대학교의 장현유 교수 연구팀과 공동으로 연구를 진행하고 있다.
우량 균주 확보와 동시에 최적 배양 조건 등 인공재배를 위한 중요 기술을 연구하고 있다.
이런 연구 결과에 힘입어 지난 6월에는 장흥에서 열린 한국 버섯학회 하계 학술대회에서 '트뤼프 기내배양 특성 및 최적 배지 선발 연구'를 발표해 우수상을 받은 바 있다.
연구 담당자인 김현석 연구사는 "트뤼프 균사체 대량증식 기술 개발로 트뤼프 인공재배 기틀을 마련했다"며 "앞으로도 유망 산림 버섯 소득 작물을 발굴하는 것은 물론 지역 재배 특성에 적합한 신품종 개발에 주력하겠다"고 말했다.
전라남도 산림자원연구소는 지금까지 버섯 연구 노하우를 토대로 전남지역 버섯 재배 농가들의 경쟁력 향상과 일자리 창출을 위해 버섯 재배 기술교육을 하고 있다.
버섯 재배 기술교육 문의는 전라남도 산림자원연구소 시험연구팀에 하면 된다.